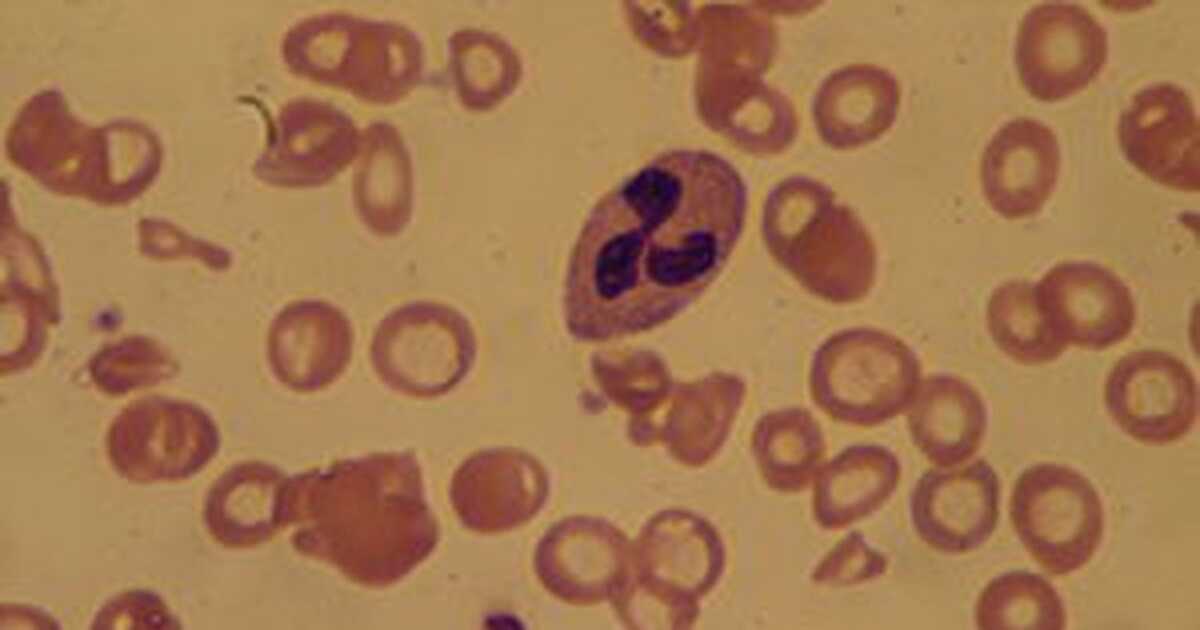
SUS oferece novo medicamento para pacientes com anemia por deficiência de ferro

Visão microscópica de células de pessoa com anemia por deficiência de ferro / Agência Brasil
Os pacientes atendidos no Sistema Único de Saúde (SUS) que sofrem de anemia por falta de ferro e têm sintomas adversos ao tomar o medicamento sulfato ferroso, agora têm uma nova opção de tratamento. O fármaco ferripolimaltose, que acaba de ser incluído na Rede SUS, traz mais uma opção aos pacientes com Anemia por Deficiência de Ferro.
Essa deficiência é um problema de saúde grave, causado pela falta de ferro, nutriente essencial no organismo para produzir as células do sangue e garantir que o oxigênio chegue a todas as partes do corpo. Quando os níveis de ferro estão baixos, a pessoa pode sentir cansaço extremo, fraqueza, falta de ar e até dificuldades de concentração.
Esse tipo de anemia afeta a saúde de crianças e mulheres em fase pré-menopausa e atinge principalmente pessoas de baixa renda, que muitas vezes não conseguem garantir uma alimentação adequada em ferro.
A doença é uma das condições nutricionais mais comuns no mundo, atingindo 30% da população. Em 2023, o Ministério da Saúde gastou R$ 326,4 milhões em internações decorrentes de anemia em hospitais públicos no país.
Com a chegada da ferripolimaltose, quem tem intolerância ao sulfato ferroso – medicamento disponível no SUS para tratar a anemia por deficiência de ferro – poderá fazer o tratamento sem os efeitos indesejados, como dores de estômago e náuseas. Isso vai garantir que mais pessoas possam ter o tratamento adequado.
Essa novidade no SUS é um passo importante para melhorar a qualidade de vida de milhares de brasileiros que convivem com a anemia.
Os principais sinais e sintomas da anemia são:
- cansaço generalizado;
- falta de apetite;
- palidez de pele e mucosas (parte interna do olho e gengivas, por exemplo);
- menor disposição para o trabalho;
- dificuldade de aprendizagem nas crianças.
O Ministério da Saúde reforça que nesses casos, o médico deverá ser procurado, para diagnóstico e conduta para o tratamento.
*Com informações do Ministério da Saúde

Deixe um comentário